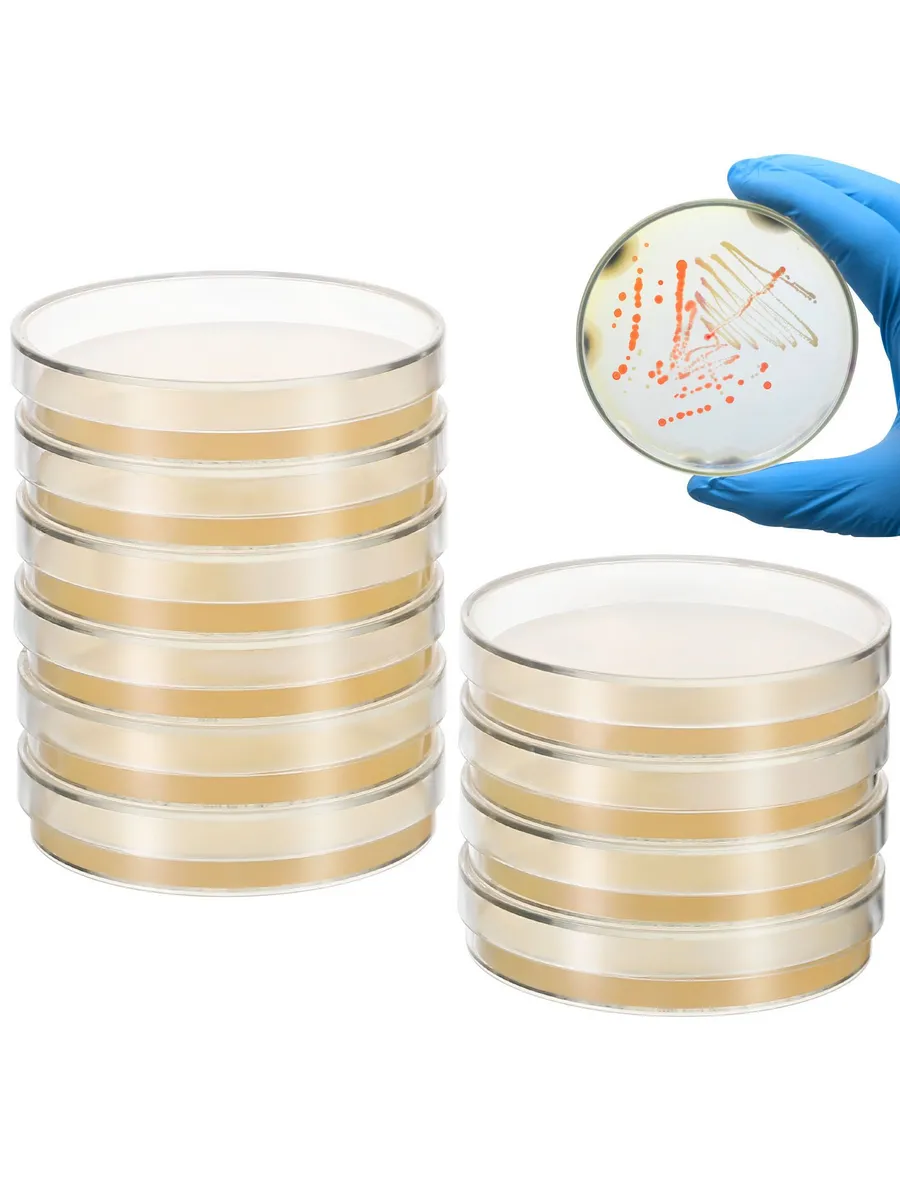

Чашки петри упаковка
Чашки петри упаковка 107 фотографий
Пансионат вороново в подмосковье
Почему охота плакать
Телефон поликлиники школьная пушкин
Норколут через сколько придут
Ассасин крид синдикат хаттаб
Как убрать рекламу в игре сокровища пиратов
Регулирует гражданство правовые отношения
Песня мамина коса
Страховая ресо спб телефон
Влияние туризма на страну
Страница кассовой книги
Группа елка песни
Картинки постели любовь
Повязки пам
Литература 6 класс 13 подвиг геракла слушать
Зерно суслик
Способы влияния природы на общество
Временный таргетинг
All you need одежда
Приставка слова заросли